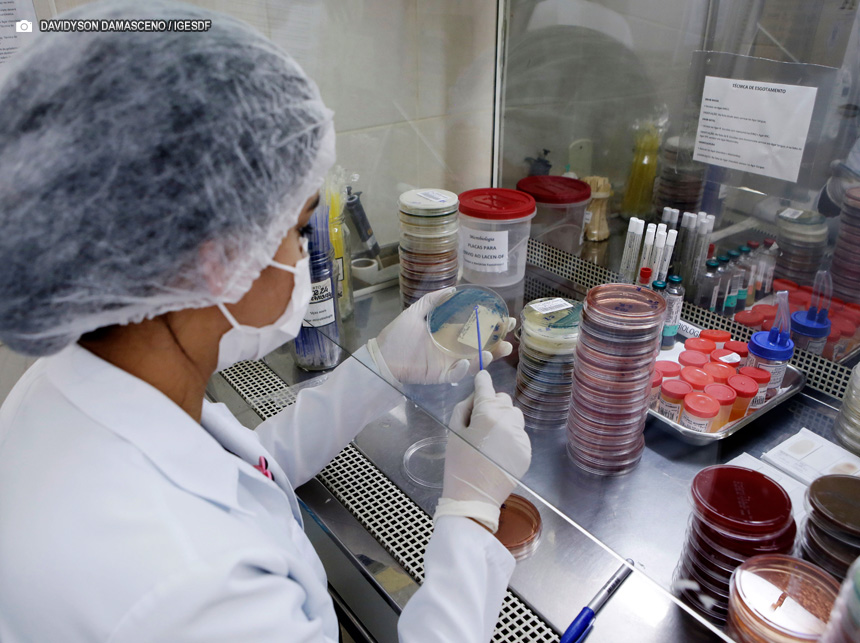
Nova técnica agiliza tratamento de pacientes com antibióticos no HRSM

Foi sancionada, nesta segunda-feira (22), a Lei n º 7.539/24 que estabelece o programa Banco Vermelho, uma iniciativa de conscientização, prevenção, informação e sensibilização sobre o enfrentamento à violência contra a mulher e o feminicídio no Distrito Federal. O objetivo é criar um ambiente de reflexão e apoio às vítimas de violência de gênero.

Programa Banco Vermelho: espaço para reflexão e defesa da mulher ficará um tempo em cada espaço público | Foto: Vinicius de Melo/SMDF
“A visibilidade dos bancos vermelhos em locais estratégicos não apenas visa à conscientização da população, mas também oferece um meio de apoio e informação direta às vítimas”
Giselle Ferreira
secretária da Mulher
A implementação do programa envolve a instalação de bancos pintados de vermelho em espaços públicos de grande circulação no DF. A ação, que se alinha aos termos da Lei Maria da Penha, define violência contra a mulher como qualquer ação ou omissão baseada no gênero que cause morte, lesão, sofrimento físico, sexual ou psicológico, e dano moral ou patrimonial.
“A iniciativa busca envolver a comunidade em uma discussão mais ampla sobre a importância de combater o feminicídio e a violência contra a mulher, promovendo um ambiente de segurança e suporte”, resume a secretária da Mulher, Giselle Ferreira. “A visibilidade dos bancos vermelhos em locais estratégicos não apenas visa à conscientização da população, mas também oferece um meio de apoio e informação direta às vítimas.”
Além do impacto visual, serão adicionadas frases que estimulem a reflexão sobre a temática do enfrentamento ao feminicídio e à violência contra a mulher. A prioridade será dada à pintura de bancos já existentes. Os bancos também terão um QR Code que direciona para a página específica da Procuradoria Especial da Mulher da Câmara Legislativa do Distrito Federal (CLDF) e da Secretaria da Mulher (SMDF), onde consta uma lista de serviços disponíveis às mulheres vítimas de violência de gênero.
Instituto Banco Vermelho
Outra ação em andamento é a parceria do GDF com o Instituto Banco Vermelho, por meio de um termo de intenção para erradicação do feminicídio com a proposta de instalar bancos vermelhos de grandes proporções em áreas movimentadas do DF. O primeiro ficou um tempo, no início deste mês, na Praça do Buriti, onde passou a fazer parte do dia a dia do cidadão brasiliense ao chamar a atenção para a iniciativa.
Ao firmarem o compromisso, o GDF e o instituto se comprometeram a atuar de forma conjunta e realizar ações culturais e educativas voltadas ao tema com o objetivo de atingir o maior número de pessoas. A instalação da estrutura é o pontapé das ações, além de ser a marca registrada da associação na luta contra o feminicídio. O banco vem acompanhado de uma mensagem para reflexão e informações dos canais de ajuda para as vítimas, e terá uma itinerância por espaços de circulação do DF para chegar a mais pessoas.